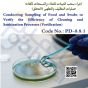
Procedure   Verification

Calibration Procedures for Measuring Equipment
-
1350L.E.
/ 1500L.E. -
(0)
اجراء المعايرة لمعدات القياس
Ensuring Accuracy: The Key to Quality and Safety in Measurement Equipment Calibration
In the world of food and pharmaceutical industries, accuracy is not a luxury, but an absolute necessity. Regularly calibrating measuring equipment (scales, temperature probes, pressure gauges) according to the stringent procedure PD-8.7A is not just a compliance requirement; it is the cornerstone for ensuring:
-
Your Product Quality: Accurate measurements mean consistent mixes, correct weights, and optimal processing conditions, guaranteeing final product quality and customer satisfaction.
-
Your Food Safety: Calibrating devices like temperature and pressure monitors is your first line of defense against microbiological hazards. Their accuracy ensures the effectiveness of pasteurization and sterilization processes, protecting consumers and your reputation.
-
Compliance & Reliability: The PD-8.7A calibration procedure is specifically designed for compliance with:
-
ISO 22000:2018 (Clause 8.3): Confirming accuracy of monitoring and measuring resources.
-
BRCGS Food Safety Issue 9 (Clause 6.4): Regular calibration of equipment against recognized standards.
-
Meeting these global standards opens markets and builds customer trust.
-
What does the PD-8.7A procedure offer your team?
-
Complete Clarity: Detailed, step-by-step instructions for calibrating various device types.
-
Full Traceability: Precise documentation of every calibration and its results, audit-ready at any time.
-
Sound Decision-Making: Reliable measurement data is the foundation for corrective actions and continuous improvement.
-
Cost Savings: Preventing shipment rejections, reducing waste, and avoiding non-conformance fines.
Don't let doubts compromise your quality or threaten product safety. Strictly implementing the PD-8.7A calibration procedure is your sure investment in compliance, quality, safety, and sustainable business success. Contact your Quality Assurance team today to ensure all your measurements are on track!
No customer reviews for the moment.



 العربية
العربية